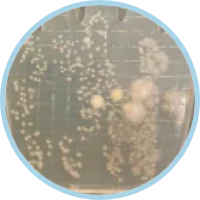

人やペット、地球にやさしいお洗濯
洗濯後のオゾン水は〈酸素〉と〈水〉に戻るので、薬剤のような残留性は一切ありません。デリケートな赤ちゃんやペット、アレルギー体質やお肌の弱い方の衣類にも安心してご使用いただけます。


取り付けるだけで毎日の洗濯が
“プロ仕様のクリーニング品質”に

洗濯しても繰り返す嫌な
臭いを原因から除去。

オゾン水は効果を発揮したのち、酸素と水に戻るからとっても安全

プロのクリーニング現場でも使われる
“除菌力”をご家庭に。


ELEOZONは本当に雑菌に効いているの?
入浴後の残り湯をELEOZONで15分循環したものと、そのままの残り湯を24時間培養しました。

残り湯そのまま

残り湯をELEOZON
で15分循環

※実験のための使用(ELEOZONは家庭洗濯機専用商品です)
生乾き臭の黒幕=モラクセラ菌を
生乾き臭の主因とされるモラクセラ菌に対して、
ELEOZONのオゾン水で99.99996%の低減を確認しました。


| 受託者 | 株式会社ビオスタ |
|---|---|
| 試験日 | 2019年4月19日 |
| 試験機関 | 株式会社プロテクティア |
| 試験場所 | 大阪大学 産業科学研究所 インキュベーション棟 |
| 試験責任者 | 株式会社プロテクティア |
ニオイの原因となる雑菌の増殖を抑えられるなら、
洗濯槽のニオイレベルも下がるはず!
27年間一度も槽洗浄していない洗濯機で実験。
事前洗浄なし、クリーナー不使用、オゾン水だけで槽洗浄(3回)

タバコを吸わない方が
喫煙室に入る苦しさ
ニオイレベル

約 95 %
低減

通常の室内以下の臭気
ニオイと菌だけじゃない!
(4.60 log)2,002,500 → 50 pfu/mL
(>5.08 log)1,212,500 → <10 pfu/mL(約12万分の1以下)
| 受託者 | 株式会社ビオスタ |
|---|---|
| 試験日 | 2019年4月19日 |
| 試験機関 | 株式会社プロテクティア |
| 試験場所 | 大阪大学 産業科学研究所 インキュベーション棟 |
|---|---|
| 試験責任者 | 株式会社プロテクティア |

洗濯後のオゾン水は〈酸素〉と〈水〉に戻るので、薬剤のような残留性は一切ありません。デリケートな赤ちゃんやペット、アレルギー体質やお肌の弱い方の衣類にも安心してご使用いただけます。
ご家庭の洗濯機に取り付けて使える「ELEOZON(エレオゾン)」の仕組みや効果を、わかりやすくまとめた紹介動画です。
実際の設置方法や、どのようにオゾン水が活用されるのかをご確認いただけます。


ご家庭でも導入できる価格に抑えるため、ダイヤモンド電極を独自技術で改良しました。

 1
1
 2
2
 3
3
洗濯終了後は、毎回必ず水栓を完全に閉じてください。
水栓を開けたままにすると、地震や振動等により予期せぬ水漏れが発生し、家具や家財に損害を与えるおそれがあります。

クリーニング用クエン酸スティック一般販売時2本のところ、4本進呈
面倒なユーザー登録は不要
ギフトにされる場合はご連絡ください
更に!